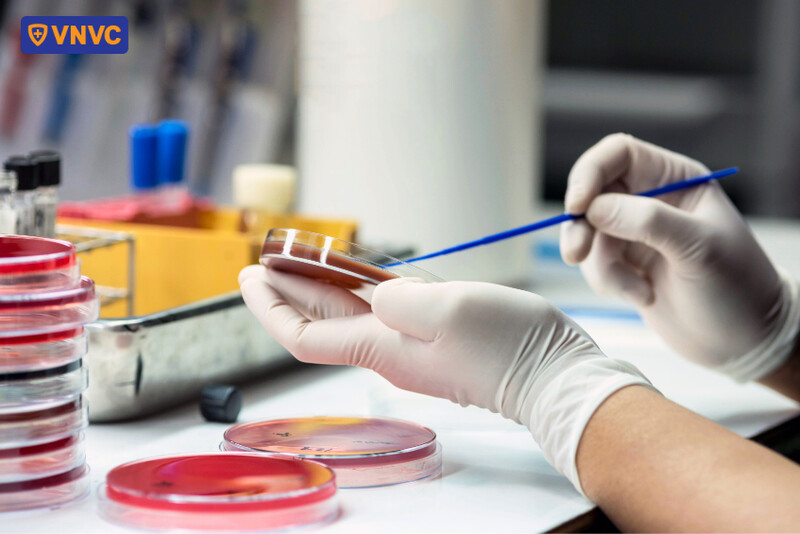
xét nghiệm nuôi cấy vi khuẩn

Xét nghiệm ho gà: 3 phương pháp chẩn đoán chính xác hiện nay

11:16 20/08/2025

Quản lý Y khoa
Hệ thống tiêm chủng VNVC
Xét nghiệm ho gà là các phương pháp thường được sử dụng để phát hiện và xác định sự hiện diện của vi khuẩn Bordetella pertussis, tác nhân chính gây bệnh. Căn bệnh này không chỉ ảnh hưởng đến sức khỏe cá nhân mà còn có khả năng lây nhiễm cao trong cộng đồng, đặc biệt ở trẻ em và những đối tượng yếu thế.
| ThS.BS Nguyễn Văn Quảng - Quản lý Y khoa vùng 4 - miền Bắc, Hệ thống Tiêm chủng VNVC cho biết: "ThS.BS Nguyễn Văn Quảng - Quản lý Y khoa vùng 4 - miền Bắc, Hệ thống Trung tâm tiêm chủng VNVC, xét nghiệm ho gà là yếu tố then chốt nhằm phát hiện sớm bệnh, kịp thời điều trị và ngăn ngừa nguy cơ lây lan trong cộng đồng. Nếu không được phát hiện kịp thời, căn bệnh này có thể dẫn đến hàng loạt biến chứng nghiêm trọng như: Suy hô hấp, viêm phổi, não thiếu oxy, viêm não, gãy xương sườn... thậm chí có nguy cơ dẫn đến ngừng thở và tử vong." |

Vì sao cần xét nghiệm bệnh ho gà?
Xét nghiệm ho gà đóng vai trò quan trọng trong chẩn đoán, kiểm soát và phòng ngừa hiệu quả căn bệnh này. Phương pháp này đặc biệt quan trọng ở những đối tượng nguy cơ cao, dễ mắc bệnh và trở nặng, như trẻ nhỏ, phụ nữ mang thai, người cao tuổi, người có hệ miễn dịch yếu.
Đây là bệnh truyền nhiễm cấp tính có khả năng lây lan nhanh qua đường hô hấp, thường gặp nhất là ở trẻ em. Nếu không được phát hiện và điều trị kịp thời bằng các phương pháp xét nghiệm, bệnh này có thể dẫn đến hàng loại biến chứng nghiêm trọng cho sức khỏe người bệnh ở thể nặng như suy hô hấp, viêm phổi, não thiếu oxy, viêm não, gãy xương sườn, xuất huyết kết mạc hay thậm chí là ngừng thở và gây tử vong.
⇒ Tham khảo thêm: Bệnh ho gà ở trẻ em

Mặt khác, triệu chứng ban đầu của bệnh ho gà thường không điển hình, như không sốt hoặc sốt nhẹ, viêm đường hô hấp trên, mệt mỏi, ho, chán ăn. Do đó, nếu chỉ dựa vào các dấu hiệu lâm sàng ban đầu mà không thực hiện xét nghiệm sẽ rất khó để xác định bệnh chính xác. Nhiều người còn tự ý mua thuốc điều trị khi có triệu chứng viêm đường hô hấp trên, dẫn đến điều trị sai bệnh, khiến bệnh càng nặng thêm.
Ngoài ra, xét nghiệm cho phép phát hiện sớm vi khuẩn gây bệnh, từ đó xác định được nguồn lây, hướng dẫn điều trị đúng liệu trình và tránh lây lan bệnh trong cộng đồng. Xác định chính xác ca bệnh còn là để thực hiện sớm các biện pháp cách ly và bảo vệ các đối tượng nguy cơ cao, đặc biệt là những người thân trong gia đình.
Nhờ vào xét nghiệm kết hợp cùng tiêm phòng giúp kiểm soát bệnh hiệu quả hơn, góp phần nâng cao sức khỏe cộng đồng, đồng thời giảm thiểu những ảnh hưởng nặng nề cho sức khỏe.
Các phương pháp xét nghiệm ho gà phổ biến hiện nay
Hiện có 3 phương pháp xét nghiệm phổ biến nhất, bao gồm: Xét nghiệm PCR, xét nghiệm nuôi cấy vi khuẩn và xét nghiệm huyết thanh học.
1. Xét nghiệm PCR
Xét nghiệm ho gà PCR thường được sử dụng để chẩn đoán bệnh trong hầu hết các trường hợp. Xét nghiệm PCR là phương pháp có độ đặc hiệu cao, có khả năng phát hiện số lượng vi khuẩn rất nhỏ, dù còn sống hay đã chết. Đây còn là phương pháp xét nghiệm không bị ảnh hưởng bởi việc sử dụng thuốc kháng sinh trước đó. Kết quả của xét nghiệm PCR thường có trong vòng 1 - 2 ngày.

2. Xét nghiệm nuôi cấy vi khuẩn
Xét nghiệm bằng phương pháp nuôi cấy vi khuẩn là phương pháp tiêu chuẩn để chẩn đoán bệnh với độ nhạy khoảng 20 - 80%. Một số yếu tố làm giảm độ nhạy của phương pháp nuôi cấy vi khuẩn bao gồm thời gian mắc bệnh kéo dài tính đến thời điểm lấy mẫu bệnh phẩm, bệnh nhân đã sử dụng thuốc kháng sinh trước đó và đã từng tiêm chủng.
Phương pháp này thường cho kết quả chính xác nhất khi thực hiện trong 2 tuần đầu tiên sau khi bắt đầu ho. Mẫu xét nghiệm sau khi lấy sẽ được gửi đến phòng xét nghiệm. Các tế bào trong mẫu được nuôi cấy đến khi có đủ để xét nghiệm, kiểm tra xem có vi khuẩn ho gà hay không. Kết quả xét nghiệm thường có sau khoảng 1 tuần.
3. Xét nghiệm huyết thanh học
Xét nghiệm huyết thanh học nhằm phát hiện sự hiện diện của kháng thể đặc hiệu trong huyết thanh người bệnh chống lại vi khuẩn ho gà. Phương pháp xét nghiệm huyết thanh học nhằm hỗ trợ chẩn đoán các ca nhiễm, đánh giá tình trạng miễn dịch của cá nhân hay cộng đồng đối với bệnh, cũng như xác định hiệu quả tiêm chủng vắc xin.
Xét nghiệm huyết thanh học có thể thực hiện từ 2 - 12 tuần sau khi người bệnh bắt đầu ho. Do đó, xét nghiệm có thể được chỉ định thực hiện sau khi xét nghiệm nuôi cấy hoặc PCR không đưa ra được kết quả chính xác.
Khi xét nghiệm huyết thanh học, các chuyên gia chăm sóc sức khỏe sẽ lấy mẫu máu từ tĩnh mạch cánh tay của bệnh nhân bằng một cây kim nhỏ. Sau khi kim được đưa vào, một lượng máu nhỏ sẽ được thu thập vào lọ hoặc ống nghiệm. Đây là phương pháp xét nghiệm đơn giản, dễ thực hiện với tổng thời gian thực hiện chưa chỉ khoảng vài phút. (1)
Khi nào cần xét nghiệm ho gà?
Xét nghiệm là yếu tố then chốt nhằm phát hiện bệnh sớm, kịp thời điều trị và ngăn ngừa nguy cơ lây lan ho gà trong cộng đồng. Việc xét nghiệm nên được thực hiện ngay khi có các dấu hiệu nghi ngờ mắc bệnh như ho kéo dài, ho từng cơn dữ dội, kèm theo tiếng rít khi hít vào, nôn ói sau ho hoặc khó thở mà không rõ nguyên nhân.
Đặc biệt, với trẻ sơ sinh và trẻ nhỏ, xét nghiệm càng là yếu tố cấp thiết. Đây là nhóm có hệ miễn dịch non nớt, dễ gặp biến chứng nặng như viêm phổi, viêm não, ngưng thở, mất nước nghiêm trọng hoặc thậm chí tử vong. Trẻ mắc bệnh còn phải đối mặt với nguy cơ suy dinh dưỡng và ảnh hưởng phát triển lâu dài và tương lai của trẻ nếu không được phát hiện và điều trị kịp thời. Đáng lưu ý, trẻ dưới 12 tháng tuổi là đối tượng có tỷ lệ tử vong cao nhất khi mắc bệnh.
Ở người lớn, bệnh thường âm thầm hơn, chỉ biểu hiện bằng triệu chứng ho kéo dài trên 2 tuần, dễ bị nhầm với viêm phế quản, dị ứng hoặc các bệnh đường hô hấp khác. Do đó, người lớn, đặc biệt là phụ nữ mang thai, nhân viên y tế, giáo viên hoặc những người làm việc trong môi trường tập thể, tiếp xúc với trẻ nhỏ nên được xét nghiệm sớm ngay khi có dấu hiệu nghi ngờ, tránh vô tình trở thành nguồn lây cho những người xung quanh.

Ngoài ra, người từng tiếp xúc gần với ca bệnh ho gà như người thân trong gia đình, người chăm sóc, bạn học, đồng nghiệp cùng phòng… cũng cần được xét nghiệm, ngay cả khi chưa có triệu chứng. Việc phát hiện sớm những ca nhiễm tiềm ẩn giúp ngăn ngừa lây lan sang người khác, nhất là trẻ chưa đủ tuổi tiêm vắc xin. Xét nghiệm nhóm đối tượng này cũng góp phần quan trọng trong việc phát hiện và kiểm soát ổ dịch, bảo vệ sức khỏe cộng đồng.
Có thể thấy, xét nghiệm không chỉ cần thiết cho người có triệu chứng mà còn là biện pháp dự phòng chủ động cho những ai thuộc nhóm nguy cơ hoặc từng tiếp xúc gần ca bệnh. Đây là hành động thiết thực giúp bảo vệ bản thân, gia đình và cộng đồng khỏi bệnh truyền nhiễm nguy hiểm có thể phòng ngừa hiệu quả.
Nên làm xét nghiệm ho gà ở đâu?
Để thực hiện xét nghiệm một cách hiệu quả, chính xác, bạn nên lựa chọn những bệnh viện uy tín, có đầy đủ trang thiết bị cũng như máy móc tiên tiến để thực hiện xét nghiệm. Vậy thực hiện phương pháp này ở đâu? Hệ thống Bệnh viện Đa khoa Tâm Anh là nơi có đội ngũ bác sĩ chuyên khoa hô hấp giàu kinh nghiệm, giỏi chuyên môn sẵn sàng khám và tư vấn tận tình cho người bệnh. Ngoài ra, Bệnh viện Tâm Anh còn có phòng xét nghiệm hiện đại, đáp ứng được nhu cầu chẩn đoán và điều trị các bệnh lý về đường hô hấp.
Để thăm khám và xét nghiệm ho gà tại Hệ thống Bệnh viện Đa khoa Tâm Anh, bệnh nhân có thể đến trực tiếp các bệnh viện tại TP.HCM và Hà Nội. Ngoài ra, để tiết kiệm thời gian, người bệnh cũng có thể gọi điện thoại hoặc truy cập website tamanhhospital.vn để đặt lịch khám với bác sĩ mong muốn, trong khung giờ phù hợp nhất với bản thân.
Tùy thuộc vào nhu cầu cũng như tình trạng sức khỏe, bệnh nhân sẽ được bác sĩ chỉ định thực hiện các phương pháp xét nghiệm thích hợp. Cần lưu ý rằng, bệnh này có khả năng lây lan mạnh qua đường hô hấp, do đó bệnh nhân cần trang bị đầy đủ khẩu trang khi ở nhà hoặc ra ngoài, rửa tay thường xuyên và hạn chế tiếp xúc với người xung quanh khi có dấu hiệu nghi ngờ bệnh.
Xét nghiệm ho gà không chỉ cần thiết cho những người xuất hiện triệu chứng bệnh, mà còn có thể được xem là phương pháp phòng ngừa chủ động cho những người thuộc nhóm nguy cơ cao hoặc có tiếp xúc gần với ca bệnh. Khi có dấu hiệu nghi ngờ mắc bệnh này, bệnh nhân nên đến bệnh viện để được thăm khám và chỉ định xét nghiệm ngay, để bảo vệ sức khỏe bản thân, gia đình và cả cộng đồng.
- Whooping Cough Tests. (2024). Medlineplus.gov. https://medlineplus.gov/lab-tests/whooping-cough-diagnosis/







